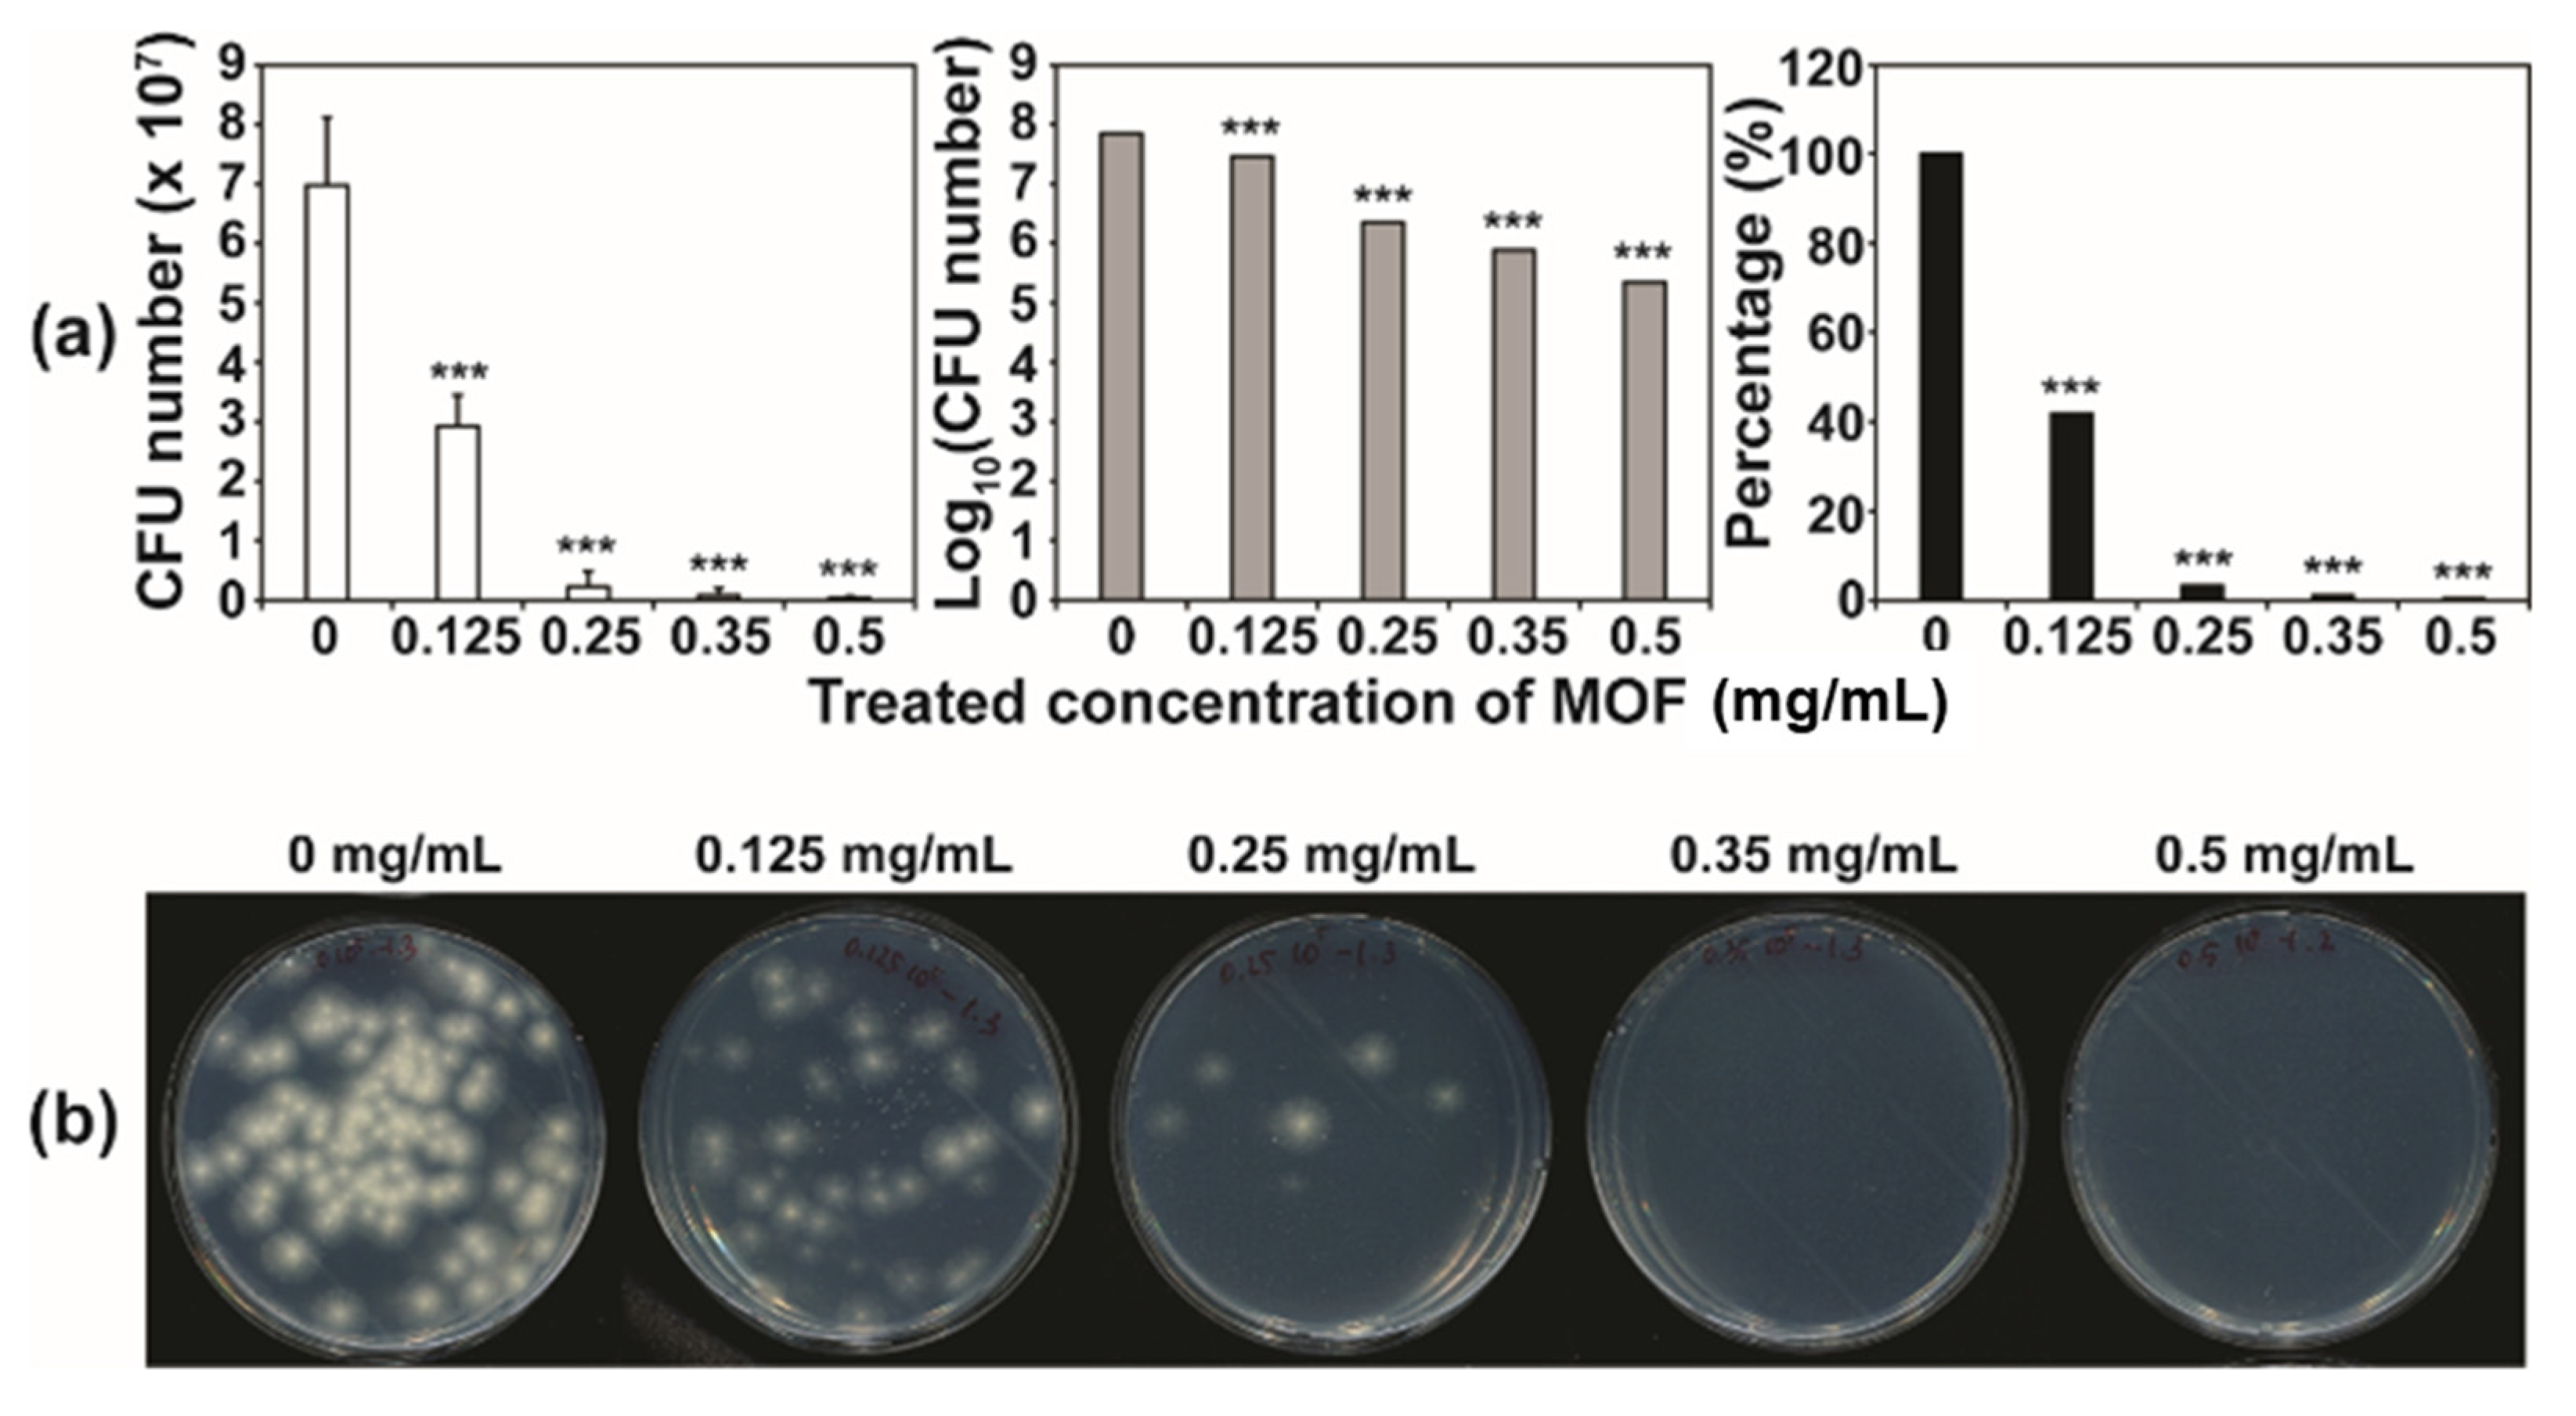
Applsci 12 00260 g004

Copper(II)-MOF Containing Glutarate and 4,4′-Azopyridine and Its Antifungal Activity
Abstract
:1. Introduction
2. Materials and Methods
2.1. Instrumentation
2.2. Preparation of [Cu2(Glu)2(AZPY)]·3H2O (Cu(AZPY)-MOF)
2.3. X-ray Crystallography
2.4. Stability and Metal Ion Release Test
2.5. AZPY Ion Release Test
2.6. Fungal Strains and Antifungal Test
2.7. Measurement of the Levels of H2O2 and NOx
3. Results and Discussion
3.1. Structure Description
3.2. Antifungal Activity
3.3. Mechanisms of the Antifungal Activity of Cu(AZPY)-MOF
4. Conclusions
Supplementary Materials
Author Contributions
Funding
Institutional Review Board Statement
Informed Consent Statement
Data Availability Statement
Acknowledgments
Conflicts of Interest
References
- Furukawa, H.; Cordova, K.E.; O’Keeffe, M.; Yaghi, O.M. The chemistry and applications of metal-organic frameworks. Science 2013, 341, 6149. [Google Scholar] [CrossRef] [Green Version]
- Marshall, R.J.; Forgan, R.S. Postsynthetic modification of zirconium metal-organic frameworks. Eur. J. Inorg. Chem. 2016, 27, 4310–4331. [Google Scholar] [CrossRef]
- Sheberla, D.; Bachman, J.C.; Elias, J.S.; Sun, C.J.; Horn, Y.S.; Dinca, M. Conductive MOF electrodes for stable supercapacitors with high areal capacitance. Nat. Mater. 2017, 16, 220–224. [Google Scholar] [CrossRef]
- Deng, H.; Grunder, S.; Cordova, K.E.; Valete, C.; Furukawa, H.; Hmadah, M.; Gándara, F.; Whalley, A.C.; Liu, Z.; Asahina, S.; et al. Large-Pore Apertures in a Series of Metal-Organic Frameworks. Science 2012, 336, 1018–1023. [Google Scholar] [CrossRef] [Green Version]
- McCarver, G.A.; Rajeshkumar, T.; Vogiatzis, K.D. Computational catalysis for metal-organic frameworks: An overview. Coord. Chem. Rev. 2021, 436, 213777. [Google Scholar] [CrossRef]
- Biswas, S.; Voort, P.V.D. A general strategy for the synthesis of functionalised UiO-66 frameworks: Characterisation, stability and CO2 adsorption properties. Eur. J. Inorg. Chem. 2013, 12, 2154–2160. [Google Scholar] [CrossRef]
- McDonald, T.M.; Mason, J.A.; Kong, X.; Bloch, E.D.; Gygi, D.; Dani, A.; Crocellà, V.; Giordanino, F.; Odoh, S.O.; Drisdell, W.S.; et al. Cooperative insertion of CO2 in diamine-appended metal-organic frameworks. Nature 2015, 519, 303–308. [Google Scholar] [CrossRef]
- Patil, R.S.; Banerjee, D.; Zhang, C.; Thallapally, P.K.; Atwood, J.L. Selective CO2 Adsorption in a Supramolecular Organic Framework. Angew. Chem. Int. Ed. 2016, 55, 4523–4526. [Google Scholar] [CrossRef]
- Lin, Z.-J.; Liu, T.-F.; Huang, Y.-B.; Lu, J.; Cao, R. A guest-dependent approach to retain permanent pores in flexible metal-organic frameworks by cation exchange. Chem.-Eur. J. 2012, 18, 7896–7902. [Google Scholar] [CrossRef]
- He, Y.; Zhou, W.; Krishnad, R.; Chen, B. Microporous metal–organic frameworks for storage and separation of small hydrocarbons. Chem. Commun. 2012, 48, 11813–11831. [Google Scholar] [CrossRef]
- Sumida, K.; Rogow, D.L.; Mason, J.A.; McDonald, T.M.; Bloch, E.D.; Herm, Z.R.; Bae, T.-H.; Long, J.R. Carbon dioxide capture in metal-organic frameworks. Chem. Rev. 2012, 112, 724–781. [Google Scholar] [CrossRef]
- Suh, M.P.; Park, H.J.; Prasad, T.K.; Lim, D.-W. Hydrogen storage in metal-organic frameworks. Chem. Rev. 2012, 112, 782–835. [Google Scholar] [CrossRef]
- Foo, M.L.; Matsuda, R.; Kitagawa, S. Functional hybrid porous coordination polymers. Chem. Mater. 2014, 26, 310–322. [Google Scholar] [CrossRef]
- Cadiau, A.; Adil, K.; Bhatt, P.M.; Belmabkhout, Y.; Eddaoudi, M. A metal-organic framework–based splitter for separating propylene from propane. Science 2016, 353, 137–140. [Google Scholar] [CrossRef]
- Cui, X.; Chen, K.; Xing, H.; Yang, Q.; Krishna, R.; Bao, Z.; Wu, H.; Zhou, W.; Dong, X.; Han, Y.; et al. Pore chemistry and size control in hybrid porous materials for acetylene capture from ethylene. Science 2016, 353, 141–144. [Google Scholar] [CrossRef] [PubMed]
- Dias, S.S.P.; Kirillova, M.V.; Andŕe, V.; Kłak, J.; Kirillov, A.M. New tricopper(II) cores self-assembled from aminoalcohol biobuffers and homophthalic acid: Synthesis, structural and topological features, magnetic properties and mild catalytic oxidation of cyclic and linear C5–C8 alkanes. Inorg. Chem. Front. 2015, 2, 525–537. [Google Scholar] [CrossRef]
- Gu, J.; Wen, M.; Cai, Y.; Shi, Z.; Arol, A.S.; Kirillova, M.V.; Kirillov, A.M. Metal-Organic Architectures Assembled from Multifunctional Polycaboxylates: Hydrothermal Self-Assembly, Structures, and Catalytic Activity in Alkane Oxidation. Inorg. Chem. 2019, 58, 2403–2412. [Google Scholar] [CrossRef] [PubMed]
- Burgun, A.; Coghlan, C.J.; Huang, D.M.; Chen, W.; Horike, S.; Kitagawa, S.; Alvino, J.F.; Metha, G.F.; Sumby, C.J.; Doonan, C.J. Mapping-out catalytic processes in a metal-oganic framework with single-crystal-crystallography. Angew. Chem. Int. Ed. 2017, 56, 8412–8416. [Google Scholar] [CrossRef] [PubMed] [Green Version]
- Mon, M.; Rivero-Crespo, M.A.; Ferrando-Soria, J.; Vidal-Moya, A.; Boronat, M.; Leyva-Pérez, A.; Corma, A.; Hernandez-Garrido, J.C.; López-Haro, M.; Calvino, J.J.; et al. Synthesis of densely packaged, ultrasmall Pt02 clusters within a thioether-functionalized MOF: Catalytic activity in industrial reactions at low temperature. Angew. Chem. Int. Ed. 2018, 57, 6186–6191. [Google Scholar] [CrossRef] [PubMed]
- Yu, Y.; Ma, J.-P.; Zhao, C.-W.; Yang, J.; Zhang, X.-M.; Liu, Q.-K.; Dong, Y.-B. Copper(I) Metal–Organic Framework: Visual Sensor for Detecting Small Polar Aliphatic Volatile Organic Compounds. Inorg. Chem. 2015, 54, 11590–11592. [Google Scholar] [CrossRef]
- Jaros, S.W.; Sokolnicki, J.; Wołoszyn, A.; Haukka, M.; Kirillov, A.M.; Smolénski, P. A novel 2D coordination network built from hexacopper(I)-iodide clusters and cagelike aminophosphine blocks for reversible ‘‘turn-on’’ sensing of aniline. J. Mater. Chem. C 2018, 6, 1670–1678. [Google Scholar] [CrossRef]
- Dou, X.L.; Sun, K.; Chen, H.B.; Jiang, Y.F.; Wu, L.; Mei, J.; Ding, Z.Y.; Xie, J. Nanoscale metal-organic frameworks as fluorescence sensors for food safety. Antibiotics 2021, 10, 358. [Google Scholar] [CrossRef] [PubMed]
- Alessandra, B.; Ilaria, C.; Elena, F.M.; Romana, L.F.; Adolfo, S.; Fabio, P.; Graziella, M.; Gualtiero, G. Eu-doped titania nanofibers: Processing, thermal behaviour and luminescent properties. J. Nanosci. Nanotech. 2010, 10, 5183–5190. [Google Scholar] [CrossRef]
- Fragala, M.E.; Cacciotti, I.; Aleeva, Y.; Lo Nigro, R.; Bianco, A.; Malandrino, G.; Spinella, C.; Pezzotti, G.; Gusmano, G. Core–shell Zn-doped TiO2–ZnO nanofibers fabricated via a combination of electrospinning and metal–organic chemical vapour deposition. CrystEngComm 2010, 12, 3858–3865. [Google Scholar] [CrossRef]
- Horcajada, P.; Gref, R.; Baati, T.; Allan, P.K.; Maurin, G.; Couvreur, P.; Ferey, G.; Morris, R.E.; Serre, C. Metal-Organic Frameworks in Biomedicine. Chem. Rev. 2012, 112, 1232–1268. [Google Scholar] [CrossRef]
- Cunha, D.; Yahia, M.B.; Hall, S.; Miller, S.R.; Chevreau, H.; Elkäım, E.; Maurin, G.; Horcajada, P.; Serre, C. Rationale of drug encapsulation and release from biocompatible porous metal–organic frameworks. Chem. Mater. 2013, 25, 2767–2776. [Google Scholar] [CrossRef]
- McKinlay, A.C.; Morris, R.E.; Horcajada, P.; Ferey, G.; Gref, R.; Couvreur, P.; Serre, C. BioMOFs: Metal–Organic Frameworks for Biological and Medical Applications. Angew. Chem. Int. Ed. 2010, 49, 6260–6266. [Google Scholar] [CrossRef]
- Jaros, S.W.; Smolénski, P.; de Silva, M.F.C.G.; Florek, M.; Kŕol, J.; Staroniewicz, Z.; Pombeiro, A.J.L.; Kirillov, A.M. New silver BioMOFs driven by 1,3,5-triaza-7-phosphaadamantane-7-sulfide (PTA=S): Synthesis, topological analysis and antimicrobial activity. CrystEngComm 2013, 15, 8060–8064. [Google Scholar] [CrossRef]
- Jaros, S.W.; de Silva, M.F.C.G.; Florek, M.; Oliveira, M.C.; Smolénski, P.; Pombeiro, A.J.L.; Kirillov, A.M. Aliphatic Dicarboxylate Directed Assembly of Silver(I) 1,3,5-Triaza-7-phosphaadamantane Coordination Networks: Topological Versatility and Antimicrobial Activity. Cryst. Growth Des. 2014, 14, 5408–5417. [Google Scholar] [CrossRef]
- Jaros, S.W.; de Silva, M.F.C.G.; Kŕol, J.; Oliveira, M.C.; Smolénski, P.; Pombeiro, A.J.L.; Kirillov, A.M. Bioactive Silver_Organic Networks Assembled from 1,3,5-Triaza-7-phosphaadamantane and Flexible Cyclohexanecarboxylate Blocks. Inorg. Chem. 2016, 55, 1486–1496. [Google Scholar] [CrossRef]
- Jaros, S.W.; de Silva, M.F.C.G.; Florek, M.; Smolénski, P.; Pombeiro, A.J.L.; Kirillov, A.M. Silver(I) 1,3,5-Triaza-7-phosphaadamantane Coordination Polymers Driven by Substituted Glutarate and Malonate Building Blocks: Self-Assembly Synthesis, Structural Features, and Antimicrobial Properties. Inorg. Chem. 2016, 55, 5886–5894. [Google Scholar] [CrossRef] [PubMed]
- Bouson, S.; Krittayavathananon, A.; Phattharasupakun, N.; Siwayaprahm, P.; Sawangphruk, M. Antifungal activity of water-stable copper-containing metal-organic frameworks. R. Soc. Open Sci. 2017, 4, 170654. [Google Scholar] [CrossRef] [PubMed] [Green Version]
- Chiericatti, C.; Basilico, J.C.; Basilico, M.L.Z.; Zamaro, J.M. Novel application of HKUST-1 metal–organic framework as antifungal: Biological tests and physicochemical characterizations. Microporous Mesoporous Mater. 2012, 162, 60–63. [Google Scholar] [CrossRef]
- Zhuang, W.; Yuan, D.; Li, J.-R.; Luo, Z.; Zhou, H.-C.; Bashir, S.; Liu, J. Highly potent bactericidal activity of porous metal-organic frameworks. Adv. Healthc. Mater. 2012, 1, 225–238. [Google Scholar] [CrossRef] [PubMed]
- Tella, A.C.; Okoro, H.K.; Sokoya, S.O.; Adimula, V.O.; Olatunji, S.O.; Zvinowanda, C.; Ngila, J.C.; Shaibu, R.O.; Adeyemi, O.G. Characterization and Antifungal Activity of Fe(III) Metal–Organic Framework and its Nano-composite. Chem. Afr. 2020, 3, 119–126. [Google Scholar] [CrossRef] [Green Version]
- Abdelhamid, H.N.; Mahmoud, G.A.-E.; Sharmouk, W. A cerium-based MOFzyme with multi-enzyme-like activity for the disruption and inhibition of fungal recolonization. J. Mater. Chem. B 2020, 8, 7548–7556. [Google Scholar] [CrossRef]
- Jiao, S.; Li, Y.J.; Gao, Z.; Chen, R.; Wang, Y.; Zou, Z. The synthesis of an antifungal 1,2,4-triazole drug and the establishment of a drug delivery system based on zeolitic imidazolate frameworks. New J. Chem. 2019, 43, 18823–18831. [Google Scholar] [CrossRef]
- Shan, Y.; Cao, L.; Muhammad, B.; Xu, B.; Zhao, P.; Cao, C.; Huang, Q. Iron-based porous metal–organic frameworks with crop nutritional function as carriers for controlled fungicide release. J. Colloid Interface Sci. 2020, 566, 383–393. [Google Scholar] [CrossRef]
- Kim, H.-C.; Mitra, S.; Veerana, M.; Lim, J.-S.; Jeong, H.-R.; Park, G.; Huh, S.; Kim, S.-J.; Kim, Y. Cobalt(II)- coordination polymers containing glutarates and bipyridyl ligands and their antifungal potential. Sci. Rep. 2019, 9, 14983. [Google Scholar] [CrossRef]
- Veerana, M.; Kim, H.-C.; Mitra, S.; Adhikari, B.C.; Park, G.; Huh, S.; Kim, S.-J.; Kim, Y. Analysis of the effects of Cu-MOFs on fungal cell inactivation. RSC Adv. 2021, 11, 1057–1065. [Google Scholar] [CrossRef]
- Hwang, I.H.; Bae, J.M.; Kim, W.-S.; Jo, Y.D.; Kim, C.; Kim, Y.; Kim, S.-J.; Huh, S. Bifunctional 3D Cu-MOFs containing glutarates and bipyridyl ligands: Selective CO2 sorption and heterogeneous catalysis. Dalton Trans. 2012, 41, 12759–12765. [Google Scholar] [CrossRef] [PubMed]
- Bezuidenhout, C.X.; Smith, V.J.; Bhatt, P.M.; Esterhuysen, C.; Barbour, L.J. Extreme carbon dioxide sorption hysteresis in openchannel rigid metal–organic frameworks. Angew. Chem. Int. Ed. 2015, 54, 2079–2083. [Google Scholar] [CrossRef] [PubMed]
- Bezuidenhout, C.X.; Smith, V.J.; Esterhuysen, C.; Barbour, L.J. Solvent- and pressure-induced phase changes in two 3D copper glutarate-based metal–organic frameworks via glutarate (+gauche⇄−gauche) conformational Isomerism. J. Am. Chem. Soc. 2017, 139, 5923–5929. [Google Scholar] [CrossRef] [PubMed]
- Rather, B.; Zaworotko, M.J. A 3D metal-organic network, [Cu2(glutarate)2(4,4′-bipyridine)], that exhibits single-crystal to singlecrystal dehydration and rehydration. Chem. Commun. 2003, 830–831. [Google Scholar] [CrossRef]
- Chen, B.; Ji, Y.; Xue, M.; Fronczek, F.R.; Hurtado, E.J.; Mondal, J.U.; Liang, C.; Dai, S. Metal-organic framework with rationally tuned micropores for selective adsorption of water over methanol. Inorg. Chem. 2008, 47, 5543–5545. [Google Scholar] [CrossRef]
- Seco, J.M.; Fairen-Jimenez, D.; Calahorro, A.J.; Méndez-Liñán, L.; Pérez-Mendoza, M.; Casati, N.; Colacio, E.; Rodríguez-Diéguez, A. Modular structure of a robust microporous MOF based on Cu2 paddle-wheels with high CO2 selectivity. Chem. Commun. 2013, 49, 11329–11331. [Google Scholar] [CrossRef]
- Cepeda, J.; Pérez-Mendoza, M.; Calahorro, A.J.; Casati, N.; Seco, J.M.; Aragones-Anglada, M.; Moghadam, P.Z.; Fairen-Jimenez, D.; Rodríguez-Diéguez, A. Modulation of pore shape and adsorption selectivity by ligand functionalization in a series of “rob”-like flexible metal–organic frameworks. J. Mater. Chem. A 2018, 6, 17409–17416. [Google Scholar] [CrossRef]
- Shen, M.; Forghani, F.; Kong, X.; Liu, D.; Ye, X.; Chen, S.; Ding, T. Antibacterial applications of metal-organic frameworks and their composites. Compr. Rev. Food Sci. Food Saf. 2020, 19, 1397–1419. [Google Scholar] [CrossRef] [Green Version]
- Abuo-Melha, H.; Fadda, A.A. Synthesis, spectral characterization and in vitro antimicrobial activity of some new azopyridine derivatives. Spectrochim. Acta Part A 2012, 89, 123–128. [Google Scholar] [CrossRef]
- Li, P.; Li, J.; Feng, X.; Li, J.; Hao, Y.; Zhang, J.; Wang, H.; Yin, A.; Zhou, J.; Ma, X.; et al. Metal-organic frameworks with photocatalytic bactericidal activity for integrated air cleaning. Nat. Comm. 2019, 10, 2177. [Google Scholar] [CrossRef]
- Gür, S.D.; Bakhshpour, M.; Bereli, N.; Denizli, A. Antibacterial effect against both Gram-positive and Gram-negative bacteria via lysozyme imprinted cryogel membranes. J. Biomater. Sci. Polym. Ed. 2021, 32, 1024–1039. [Google Scholar] [CrossRef]
- Martínez, A.; Apip, C.; Meléndrez, M.F.; Domínguez, M.; Sánchez-Sanhueza, G.; Marzialetti, T.; Catalán, A. Dual antifungal activity against Candida albicans of copper metallic nanostructures and hierarchical copper oxide marigold-like nanostructures grown in situ in the culture medium. J. Appl. Microbiol. 2021, 130, 1883–1892. [Google Scholar] [CrossRef] [PubMed]
- Shammout, M.W.; Awwad, A.M. A novel route for the synthesis of copper oxide nanoparticles using Bougainvillea plant flowers extract and antifungal activity evaluation. Chem. Int. 2021, 7, 71–78. [Google Scholar]

Publisher’s Note: MDPI stays neutral with regard to jurisdictional claims in published maps and institutional affiliations. |
© 2021 by the authors. Licensee MDPI, Basel, Switzerland. This article is an open access article distributed under the terms and conditions of the Creative Commons Attribution (CC BY) license (https://creativecommons.org/licenses/by/4.0/).
Share and Cite
Yang, S.; Veerana, M.; Yu, N.; Ketya, W.; Park, G.; Kim, S.; Kim, Y. Copper(II)-MOF Containing Glutarate and 4,4′-Azopyridine and Its Antifungal Activity. Appl. Sci. 2022, 12, 260. https://doi.org/10.3390/app12010260
Yang S, Veerana M, Yu N, Ketya W, Park G, Kim S, Kim Y. Copper(II)-MOF Containing Glutarate and 4,4′-Azopyridine and Its Antifungal Activity. Applied Sciences. 2022; 12(1):260. https://doi.org/10.3390/app12010260
Chicago/Turabian StyleYang, Sohyeon, Mayura Veerana, Nannan Yu, Wirinthip Ketya, Gyungsoon Park, Sungjin Kim, and Youngmee Kim. 2022. "Copper(II)-MOF Containing Glutarate and 4,4′-Azopyridine and Its Antifungal Activity" Applied Sciences 12, no. 1: 260. https://doi.org/10.3390/app12010260
APA StyleYang, S., Veerana, M., Yu, N., Ketya, W., Park, G., Kim, S., & Kim, Y. (2022). Copper(II)-MOF Containing Glutarate and 4,4′-Azopyridine and Its Antifungal Activity. Applied Sciences, 12(1), 260. https://doi.org/10.3390/app12010260

